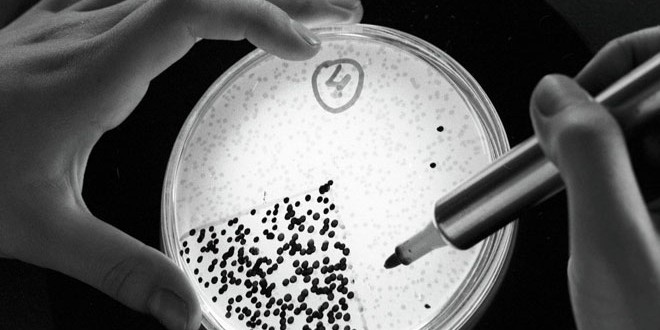

موسكو-سانا
عثر علماء البيولوجيا الروس في رفات حيوان الماموث المتجمد على كائنات حية مجهرية يمكنها تجديد الشباب.
ونقلت وكالة سبوتنيك الروسية عن الطبيب الروسي فيكتور تشيرنيافسكي قوله إن” علماء البيولوجيا أصبحوا قاب قوسين أو أدنى من التوصل إلى اكسير الشباب الدائم” موضحا أن هذا الاكسير يتألف من كائنات حية مجهرية تم العثور عليها في رفات حيوان الماموث المتجمد في إقليم ياقوتيا الروسي.
وتمكن الباحثون الروس في ياقوتيا ومدينتي يكاتيرينبورغ ونوفوسيبيرسك من اكتشاف البكتيريا “الحيوهوائية” التي تستطيع العيش في بيئة باردة في بقايا مخ الماموث.
وأظهرت دراسة أجراها الباحثون أن الكائنات الحية المجهرية المكتشفة والتي يقدر عمرها بـ 20 ألفا إلى 40 ألف سنة تزيد فئران التجارب حيوية وتمكن حتى الفئران المتقدمة في السن من الإنجاب.
ويرى العلماء إمكانية تطبيق التجربة نفسها على البشر ولا سيما أن التجارب أظهرت أن البكتيريا القادرة على تجديد الشباب لا تستطيع العيش في البيئة الباردة.
S A N A الوكالة العربية السورية للأنباء